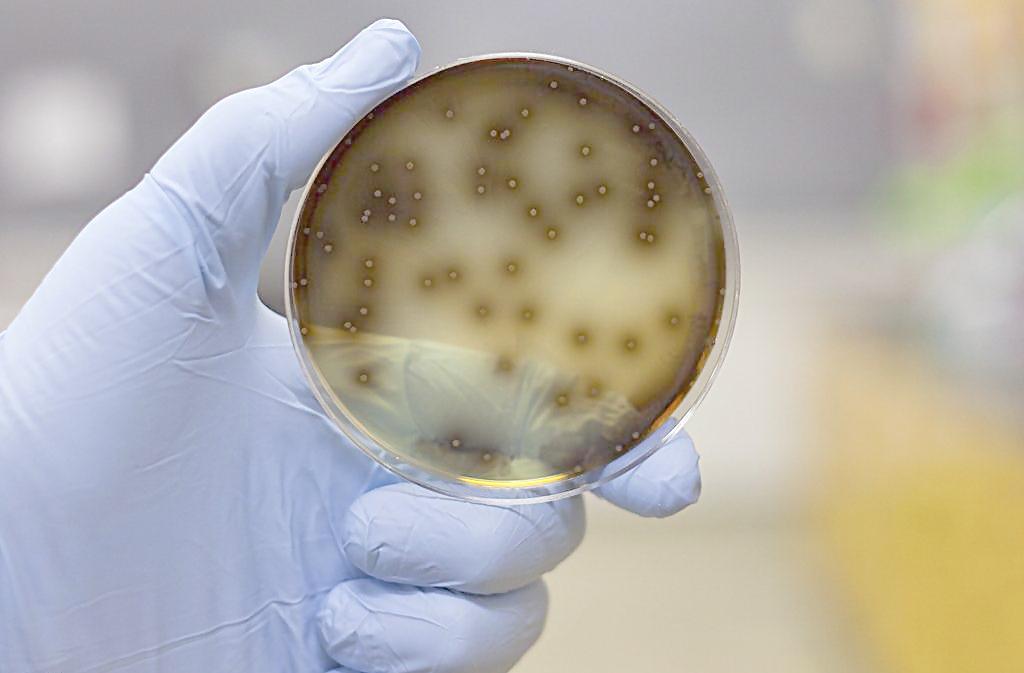
植物細胞實驗室設計方案

細胞培育室
細胞培育室簡介:
細菌培養實驗室是微生物實驗室里面的配套實驗室,細菌培養室用人工方法(使其在合適的溫度,濕度,光照度,PH值,潔凈度等環境下,使細菌生長繁殖,培養出來的細菌用于研究、鑒定和應用。廣泛用于醫藥研究。
室內要求無菌操縱,要求工作環境和條件必須保證無微生物污染和不受其它有害因素的影響.細胞培養室和設計原則是防止微生物污染和有害因素影響,要求工作環境清潔,空氣清新,干燥和無煙塵.細胞培養室的設計原則一般是無菌操縱區設在室內較少走動的內側,常規操縱和封閉培養于一室,而洗刷消毒在另一室. 與其他一般實驗室工作的主要區別在于要求保持無菌操作,避免微生物及其他有害因素的影響。一般標準的細胞培養室應包括配液室、準備室和培養室。三室既相互連接又相對獨立,各自完成培養過程中的不同操作。

細胞實驗室可培育的細胞種類 :
干細胞培養
•腫瘤細胞的培養 <>
• 上皮細胞的原代培養 <>
• 內皮細胞原代培養 <>
• 神經原細胞原代培養 <>
• 肌組織原代培養 <>
• 巨噬細胞原代培養 <>
• 293細胞培養 <>
• 細胞的冷凍保存和解凍培養 <>
• 小鼠胚胎干細胞的培養 <>
• 小鼠骨髓來源樹突狀細胞(BMDC)的培養<>
• 肺泡II型細胞分離培養 <>
• 肝枯否細胞分離培養 <>
• 原代軟骨細胞分離培養 <>
• 心肌細胞分離培養 <>
• 細胞轉染技術
備注:細胞培育室包括以上細胞品類,但不限于以上種類:
胞培養室的溫度
維持培養細胞旺盛生長,必須有恒定而適宜的溫度.不同種類的細胞對培養溫度要求也不同.人體細胞培養的標準溫度為36.5℃±0.5℃,偏離這一溫度范圍,細胞的正常代謝會受到影響,甚至死亡.培養細胞對低溫的耐受力較對高溫強,溫度上升不超過39℃時,細胞代謝與溫度成正比;人體細胞在39-40℃1小時,即能受到一定損傷,但仍有可能恢復;在40-41℃1小時,細胞會普遍受到損傷,僅小半數有可能恢復;41-42℃1小時,細胞受到嚴重損傷,大部分細胞死亡,個別細胞仍有恢復可能;當溫度在43℃以上1小時,細胞全部死亡.相反,溫度不低于0℃時,對細胞代謝雖有影響,但并無傷害作用;把細胞放進25-35℃時,細胞仍能生存和生長,但速度減慢;放在4℃數小時后,再回到37℃培養,細胞仍能繼續生長.細胞代謝隨溫度降低而減慢.當溫度降至冰點以下時,細胞可因胞質結冰受損而死亡.但是,假如向培養液中加進一定量的冷凍保護劑(二甲亞砜或甘油),可在深低溫下如-80℃或-196℃(液氮)長期保存.
細胞培養室合適的氣體環境
氣體是哺乳動物細胞培養生存必須條件之一,所需氣體主要有氧氣和二氧化碳.氧氣參與三羧酸循環,產生供給細胞生長增殖的能量和合成細胞生長所需用的各種成分.開放培養時一般把細胞置于95%空氣加5%二氧化碳混合氣體環境中.二氧化碳既是細胞代謝產物,也是細胞生長繁殖所需成分,它在細胞培養中的主要作用在于維持培養基的pH值.大多數細胞的適宜pH為7.2-7.4,偏離這一范圍對細胞培養將產生有害的影響.但細胞耐酸性比耐堿性大一些,在偏酸環境中更利于細胞生長.但有一些細胞也喜歡偏堿環境中生長,如成纖維細胞最適合pH是7.4-7.6.每種細胞都有其最適pH值.
細細胞培養實驗室的設置
細胞培養實驗室應能進行六方面的工作:無菌操作、孵育、制備、清洗、消毒滅菌處理、儲藏。

植物細胞培養實驗室設置
1.基本實驗室
1.1 洗滌間
根據工作量的大小決定其大小,一般面積控制在30-50m2。在實驗室的一側設置專用的洗滌水槽,用來清洗玻璃器皿。中央實驗臺還應配置2個水槽,用于清洗小型玻璃器皿。如果工作量大,可以購置一臺洗瓶機。準備1-2個洗液缸,專門用于洗滌對潔凈度要求很高的玻璃器皿。此外還應配置落水架、干燥箱、柜子、超聲波清洗器等。 地面應耐濕并排水良好。
1.2培養基配制間
面積60平方米左右,配備的主要儀器設備有 :冰箱、天平、微波爐、pH計、培養基分裝器、藥品柜、器械柜、抽氣泵、電爐、各種規格的培養瓶、培養皿、移液管、燒杯、量筒、容量瓶、儲藏瓶等。冰箱以體積180-200L為宜,用于儲存培養基母液、激素維生素等貴重藥品、彩色膠卷、及保存植物材料。天平應有不同感量。
1.3消毒間
配備實驗臺、高壓滅菌鍋、排風滅火設備、細菌過濾設備、干熱消毒柜、電爐等。 滅菌鍋的選擇應根據不同的要求選擇不同型號的滅菌鍋。一般實驗室可選用小型的醫用手提式高壓滅菌鍋,較大的實驗室可選用立式自動控制壓力和溫度的滅菌鍋。生產性的實驗室可選用大型的臥式滅菌鍋。
如果沒有條件的話,可以將上述工作間合并成一個準備間,要求是設備的安裝和排列要合理、房間要寬敞、明亮、透風,地面要便于清潔、防滑。
1.4無菌操作室
無菌操作室主要用于實驗材料的接種操作,所以又叫接種室。通常由里外兩間組成,外間是緩沖間,用于準備工作,還有防止污染的作用。緩沖間的門應該與接種室的門錯開,兩個門也不要同時開啟,以保證無菌室不因開門和人的進出帶進雜菌。
緩沖間內應該設有水槽、實驗臺、鞋帽架、和柜子、紫外燈。無菌操作室的內壁應當用塑鋼板或瓷磚裝修,工作人員進入操作間前要穿上消過毒的工作服和拖鞋。 室內應配有超凈工作臺,紫外燈、解剖鏡、各種接種器械等。
1.5培養室
為了控制培養室的溫度和光照時間及其強度,培養室的房間不要窗戶,但應當留一個通氣窗,并安上排氣扇。室內溫度由空調控制,光照由日光燈控制。天花板和內墻***好用塑料鋼板裝修,地面用水磨石或瓷磚鋪設,一般要分兩間,一為光照培養室,一為暗培養室。培養室外應有一預備間或走廊。
培養室應配有培養架、轉床、搖床、光照培養箱、生化培養箱、自動控時器等。日光燈一般用40W,固定在培養架的側面或擱板的下面,每層有兩支日光燈,距離在20cm,光照強度為2000-3000lx。 2.輔助實驗室 2.1鑒定室
細胞學鑒定室 其功能是對培養材料進行細胞學鑒定和研究。要求清潔、明亮、干燥,使各種光學儀器不受潮濕和灰塵污染。應配置各種顯微鏡、照相系統等。 生化分析室在以培養細胞產物為主要目的的實驗室中,應建立相應的分析化驗實驗室,以便于對培養物的有效成分隨時進行取樣檢查。 離心機、酶聯免疫檢測儀、天平、PCR儀等。 2.2、溫 室 用于試管苗的鍛煉和移植,為試管苗提供滿足生長的適宜環境條件。 常用設備有:溫室 、彌霧裝置、蔭棚、移栽床、缽、盆、基質等.

普通細胞培養室內走廊

普通細胞培養室一角

萬級層流細胞培養室
2.動物細胞培養實驗室設置
無菌條件:凈化工作室,風淋室,傳遞窗,高效過濾器,潔凈層流罩,生物安全柜,超凈工作臺,紫外燈,電熱干燥箱,濾器,高壓滅菌器,抗生素。
細胞生長條件:純水蒸餾器,純水儀,培養板,培養瓶, CO2培養箱,培養基,血清 細胞檢測條件:倒置顯微鏡,酶標儀 ,微孔板震蕩器,高速離心機,移液器 。
細胞保存條件:液氮罐 實驗室 準備間 緩沖間 培養室 。
實驗室的要求
①和緩沖間相連,緩沖間內備消毒服裝和鞋,口罩等,入內換上
②設置1—2臺超凈工作臺
③室內空氣不流通,有適當的光線,清潔,干燥
④側部可設傳遞窗,用于物品傳遞
⑤照明用熒光燈為好,消毒用紫外線燈
⑥在室內工作時,動作應輕微
準備間內設備
①大、小水槽②消毒設備③消毒后的物品和器械保藏柜④烘箱
⑤蒸餾器(包括雙蒸,三重蒸餾水)⑥玻璃器皿,培養液等⑦電爐等
注意:
①配制溶液要用新鮮的純水,配制過程避免交叉感染
②設備排列緊湊
③指定一處可暫放不污及有毒物質 準備間設備
CO2培養箱:37度+/-0.5度;能調節溫度和CO2濃度
消毒器:高壓鍋,蒸汽滅菌鍋,干燥消毒箱
冰箱:4度或-20度家用冰箱,保存一般制劑;-70度保存蛋白制劑
水質純化裝置:凈化水質用于清洗或配制培養液
另外:顯微鏡,離心機,酸度計,天平,液氮罐、真空泵等。
案例一:
名稱:某生物學研究所植物細胞實驗室
實驗室面積:500m2的實驗場地,
擁有1個層流的細胞操作間、2個普通培養操作間、1個無菌室、及配套實驗室和洗滌消毒室、緩沖房。

案例二:
以下為某干細胞治療中心萬級潔凈實驗室建設方案
一、施工原則
1、)統一施工驗收要求,做到保證工程質量、節約能源、保護環境、安全操作。
2、)萬級潔凈室施工前必須按照設計圖紙施工,并且制定詳盡的施工方案和程序
3、)施工所用的所有材料、設備必須符合設計規定并有質量鑒定文件。
二、實驗室設計依據
1、《實驗室生物安全通用要求》GB-19489-2004
2、《生物安全實驗室建筑技術規范》GB50346-2004
3、《潔凈廠房設計規范》(GB50073-2001)
4、《潔凈室施工及驗收規范》(JGJ71-90)
5、《通風與空調工程施工及驗收規范》(GB50243-2000)
6、《采暖與空調調節設計規范》(GBJ114-88)
7、《建筑設計防火規范》(GBJ 16-87)
8、《低壓配電裝置及線路設計規范》(GBJ54-83)
三、萬級干細胞實驗室凈化通風系統
萬級無菌實驗室利用送、回風量維持房間壓差;送風經初、中、高效過濾后送入室內。(回風比例為80%,新風比例為20%)
3.3干細胞實驗室結構
從保溫角度考慮實驗室的圍護及吊頂結構采用厚度為50mm的凈化實驗室專用聚苯乙烯夾心復合彩鋼板(優點:機械強度高,隔熱、隔音、防潮性能好、平整光滑、耐腐蝕、易清潔、安裝方便)。頂棚及板壁的墻角處和墻與地面、墻與吊頂采用圓弧陰陽過渡并封閉。所有配套鋁合金型材均采用優質電泳型材,以防止實驗室以后消毒時導致鋁材氧化。
3.2萬級干細胞實驗室凈化通風系統
萬級無菌實驗室利用送、回風量維持房間壓差;送風經初、中、高效過濾后送入室內。(回風比例為80%,新風比例為20%)
3.3干細胞實驗室結構
從保溫角度考慮實驗室的圍護及吊頂結構采用厚度為50mm的凈化實驗室專用聚苯乙烯夾心復合彩鋼板(優點:機械強度高,隔熱、隔音、防潮性能好、平整光滑、耐腐蝕、易清潔、安裝方便)。頂棚及板壁的墻角處和墻與地面、墻與吊頂采用圓弧陰陽過渡并封閉。所有配套鋁合金型材均采用優質電泳型材,以防止實驗室以后消毒時導致鋁材氧化。
3.4干細胞實驗室照明燈具
實驗室照明均采用專用潔凈室照明燈具(不銹鋼斜邊型吸頂式帶罩密封燈具)。特點:鏡面全內膽,照明度強,不銹鋼邊框年久不腐蝕,外形美觀,密封好、抗干擾、不積塵、易清潔。
3.5干細胞實驗室消毒
實驗室消毒采用紫外線燈照射消毒
3.6干細胞實驗室氣流組織方式
從節能角度考慮實驗室系統設計為新風+回風混合系統,采用頂送側下回的氣流組織方式。
3.7干細胞實驗室空調系統工程
萬級無菌實驗室采用風冷直接膨脹式凈化專用風管型空調機組,滿足實驗室夏季、冬季冷熱負荷,保持實驗室恒溫恒濕。
3.8干細胞實驗室防氣流倒灌系統
實驗室新風管上均安裝電動密閉閥以防止關機時空氣回流。并能封閉消毒。
干細胞實驗室平面圖
以8m*13m的大小面積為例,建立的干細胞實驗室平面圖。

科瓦特細胞培養室建設方案:
科瓦特提供實驗室整體建筑布局和裝修、空氣調節、給排水、氣體供應、電氣設計、集中控制、安防、施工工藝、檢測、培訓等多方面內容??仆咛貙嶒炇铱筛鶕蛻粢笤O計、施工,提供一站式實驗室整體供應服務!
推薦方案:
動物細胞實驗室設計 植物細胞實驗室設計
同類文章排行
- 實驗室規劃建設需要注意的地方
- 科瓦特2023年春節放假通知
- 成功簽約常熟立訊實驗室改造工程
- 喜訊,簽約完美生命科技研究院SPF動物實驗室
- 中山科瓦特國慶中秋放假通知
- 簽約中山板芙醫院PCR檢測室工程
- 喜訊 中標鴻基創能科技公司實驗室工程
- 成功簽約廣東威科質量檢測公司SPF級動物實驗室
- 2019年,科瓦特機電開工大吉
- 2019年春節放假通知
最新資訊文章
- 實驗室設計公司如何選擇
- 實驗室裝修設計方案需考慮哪些因素
- 實驗室裝修要考慮哪些因素
- 建設一個實驗室要花費多少錢,周期多長
- 實驗室裝修施工流程有哪些
- 實驗室空間如何布局
- 實驗室設計要注意那些要點
- 實驗室臺如何布局更好
- 實驗室裝修細節大揭秘
- 實驗室設計周期是多久?






